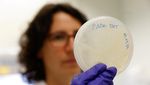
Ilmuwan di Spanyol Manfaatkan Bakteri untuk Restorasi Lukisan Dinding

Spanyol - Ilmuwan ibu dan anak asal Spanyol menggunakan bakteri untuk merestorasi lukisan dinding gereja di Valencia. Begini potretnya.
Foto Health
Ilmuwan di Spanyol Manfaatkan Bakteri untuk Restorasi Lukisan Dinding

Ahli mikrobiologi dan peneliti di Institut Penelitian Restorasi Warisan (IRP) Universitas UPV, Pilar Bosch Roig (42), memeriksa sentrifugasi sel bio-pembersih yang benar yang akan digunakan dalam pemulihan lukisan dinding gereja Santos Juanes di Valencia, Spanyol.

Restorasi Gereja Santos Juanes dipimpin oleh tim ibu-anak, Pilar Roig dan Pilar Bosch, menggunakan metode inovatif menggunakan bakteri untuk membersihkan lem membandel dari lukisan dinding abad ke-18.

Prosesnya terdiri dari menumbuhkan mikroorganisme dalam lem, yang merupakan zat yang ingin dihilangkan.

Ahli mikrobiologi melatih bakteri dengan memberi mereka sampel lem yang terbuat dari kolagen hewan.

Bakteri kemudian secara alami menghasilkan enzim untuk mendegradasi lem.

Tim keluarga kemudian mencampur bakteri dengan gel berbasis alga alami dan menyebarkannya pada lukisan - yang diambil dari dinding pada tahun 1960-an, kemudian dipaku kembali, masih tertutup lem. Setelah tiga jam, gel dihilangkan, memperlihatkan lukisan yang bebas lem.

Bosch juga telah menerapkan penggunaan bakterinya pada proyek restorasi di Pisa dan Monte Cassino di Italia dan di Santiago de Compostela di Spanyol utara. Dia sekarang melatih kelompok bakteri jenis lain untuk membersihkan dinding dari grafiti yang dicat semprot.